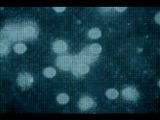

Man With A Movie Camera
258
Upload
gates open, throngs of people with; suitcases, boxes rushing towards
; train?
16.62 seconds | 498 frames
00:17:57.47 00:18:14.07